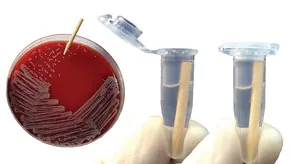
Merck smartPick Wooden inoculation picks

Merck smartPick Wooden inoculation picks
상품 한눈에 보기
1. 1.5 mL 튜브에 적합한 미니 사이즈 나무 콜로니 픽 2. 100% 미국산 화이트 버치로 제작, 생분해성 친환경 제품 3. 오토클레이브 후 바로 사용 가능, 비멸균 상태로 FDA 식품 기준 충족 4. ISO 9001, ISO 13485 및 FDA 등록 시설에서 생산 5. 1.28인치 길이, 니들 포인트 타입, 2000개 포장
브랜드: Merck Sigma
✨AI 추천 연관 상품
AI가 분석한 이 상품과 연관된 추천 상품들을 확인해보세요
연관 상품을 찾고 있습니다...
Merck smartPick™ Wooden Inoculation Picks
제품 개요
- 미생물학용 나무 콜로니 픽
- 재활용 가능하고 친환경적인 생분해성 소재 사용
- 오토클레이브 후 바로 마이크로튜브에서 사용 가능
주요 특징
- 사용 용도: 미생물 접종, 콜로니 픽업
- 포인트 형태: Needle point
- 소재: 100% 미국산 White Birch
- 제조국: 미국
- 비멸균 제품, FDA 식품 기준 충족
- ISO 9001:2008, ISO 13485:2003 인증 및 FDA 등록 제조시설 생산
사양
| 항목 | 내용 |
|---|---|
| 길이 | 1.28 in (3.25 cm) |
| 포장 단위 | Pack of 2000 ea |
| 제조사/트레이드네임 | LevGo Inc / smartPick™ |
| 포인트 형태 | Needle point |
| 적합 튜브 크기 | 1.5 mL tube |
| 멸균 여부 | Non-Sterile |
| 친환경성 | Naturally Biodegradable |
추가 정보
- 다양한 길이(1.28 in, 2.5 in, 6 in) 및 포인트 형태(needle, semi) 제공
- 미국 내 ISO 인증 및 FDA 등록 시설에서 생산
제품 이미지
배송/결제/교환/반품 안내
배송 정보
| 기본 배송비 |
| 교환/반품 배송비 |
|
|---|---|---|---|
| 착불 배송비 |
| ||
| 교환/반품 배송비 |
| ||
결제 및 환불 안내
| 결제수단 |
|
|---|---|
| 취소 |
|
| 반품 |
|
| 환급 |
|
교환 및 반품 접수
| 교환 및 반품 접수 기한 |
|
|---|---|
| 교환 및 반품 접수가 가능한 경우 |
|
| 교환 및 반품 접수가 불가능한 경우 |
|
교환 및 반품 신청
| 교환 절차 |
|
|---|---|
| 반품 절차 |
|
문의 0
로그인 후 문의를 할 수 있습니다.